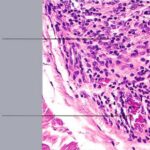

Alopecia areata = الحاصة البقعية
|
Alopecia Areata
Alopecia areata (AA) is characterized clinically by complete or nearly complete absence of hair in one or more circumscribed areas of the scalp . Clinical inflammation, typically manifested by erythema, is not obvious, and the follicular openings are preserved, a clinical finding that allows the examiner to make the assessment of a nonscarring alopecia. In active areas of involvement, hair shedding is seen, as well as some short, fractured hair shafts, including the pathognomonic “exclamation point” hair. Complete scalp involvement (alopecia totalis) may ocur suddenly or through prolonged, progressive disease. Complete or nearly complete loss of all body hair (alopecia universalis) can also occur. Involvement of the eyebrows and eyelashes and regularly spaced pits on the surface of the nails may be seen. The majority of patients with localized disease undergo spontaneous resolution, but others show persistent disease, and a few patients have permanent hair loss. “The only predictable thing about the progress of alopecia areata is that it is unpredictable” , which means essentially that one cannot reliably predict which patients will have limited disease with spontaneous resolution and which will have recurrent disease or chronic, severe disease. |
|
Histopathology.
The diagnostic pathologic feature is peribulbar lymphocytic inflammation (“swarm of bees”) affecting anagen follicles or follicles in early catagen. The inflammatory assault on anagen follicles induces a premature conversion to catagen . Consequently, the number of catagen and telogen follicles found may be marked, approaching 100% . Follicles may enter a persistent phase of telogen in which the hair shaft has already been shed, manifested by the telogen germinal unit .As follicles enter catagen, the lymphocytic infiltrate may persist around the epithelial remnant of the receding follicle and also within and surrounding the collapsed follicular sheaths. Telogen hairs show little to no perifollicular inflammation. |
|
Lymphocytes may also be seen sparsely infiltrating the matrix epithelium of anagen follicles, inducing damage to the matrical cells that includes intra- and intercellular edema, cellular necrosis, and microvesicle formation. One of the earliest findings was shown to be a loss of structural integrity of bulbar keratinocytes in the central part of the supramatrical bulb and shrinkage of hair bulbs toward a club shape . As a result of injury to bulbar melanocytes and keratinocytes, pigment casts, which are clumps of melanin pigment, may be found within the dermal papilla, the sheath of miniaturizing or regressing follicles, or the follicular epithelium . Pigment casts |
|
are more often found in trichotillomania; one interpretation of their presence in the context of AA is that here too they represent external manipulation of the hair . Pigment casts have also been found in postoperative pressure-induced alopecia, leading those authors to postulate that they resulted from the sudden conversion of follicles from anagen to catagen, as occurs in trichotillomania and AA . |
|
The inflammatory assault may produce dysmorphic follicles and shafts. Anagen hairs not sufficiently damaged so as to enter prematurely into catagen may continue to manufacture a hair shaft, one that may be small, distorted, and often nonpigmented (termed trichomalacia). The hair shaft may taper to a point so tiny and fragile that it fractures. Small, abnormal follicles called nanogen hairs are a distinctive finding in longstanding cases . They are difficult to categorize as anagen, |
|
catagen, or telogen hairs, and in transverse sections they show only a minute, incompletely keratinized hair shaft or no shaft at all. |
|
As telogen follicles reenter anagen, they again come under attack from pathogenic lymphocytes, which precipitate premature conversion to catagen once again, so that anagen duration becomes shorter and shorter and the follicles begin to miniaturize . As the follicles decrease in size they become situated more superficially, although often deeper than normal vellus hairs, with their bulbs situated in the mid to lower dermis . With disease chronicity, most of the hairs become miniaturized. Miniaturization and conversion to catagen and telogen leave many collapsed fibrous root sheaths in the subcutis. |
|
Whiting found that transversely sectioned scalp biopsies showed the diagnostic features of alopecia areata more often than vertically sectioned biopsies . He also published mean quantitative hair counts for horizontally sectioned scalp biopsies of alopecia areata. The mean terminal-ta-vellus hair ratio was similar to that seen in androgenetic alopecia , reflecting extensive miniaturization. The mean anagen-ta-telogen ratio was 73%:27%, and the total hair count (mean of 27 hairs) was 33% less than in the control group, with more severely affected patients (alopecia universalis) at the lower end of the spectrum. Others have also found that the follicular density can decrease in severe alopecia totalis and universalis of long duration (a decade or more), with scars replacing some of the follicular sheaths . |
|
Whiting and others have emphasized the use of follicular counts to aid in the diagnosis of AA when the characteristic peribulbar inflammation is missing, with a high percentage of catagen or telogen hairs and miniaturized hairs as a strong sign of AA .In one study, the presence of eosinophils around the bulb and within fibrous tracts was found to be a helpful diagnostic feature of AA, identifying it in 38 of 71 patients. In biopsies lacking peribulbar lymphocytic inflammation, eosinophils were found approximately 50% of the time . Some plasma cells may also be present. |
|
Some authors claim that in longstanding AA, the inflammatory infiltrates appear to diminish (203), whereas others believe that the degree of inflammation found on biopsy does not depend on disease duration, citing cases of longstanding AA that showed a great deal of inflammation (194). In a reappraisal of the histopathology of AA, Whiting suggested that the key factor in the histologic picture was the duration of the attack, with lymphocytes surrounding mainly terminal hair bulbs in acute episodes and involving mainly miniaturized hair bulbs in chronic, recurrent disease . In the histologic differential diagnosis, alopecia syphilitica may closely mimic active AA . Features that help to |
|
distinguish syphilitic alopecia include lymphocytes situated near the isthmus, the presence of plasma cells, an endothelial reaction, interface dermatitis, and neutrophils in the stratum corneum . Alopecia areata may also look identical to the patchy, nonscarring alopecia that occurs in the setting of systemic lupus erythematosus, which shows mononuclear cell inflammation around terminal and miniaturized anagen hair bulbs, as well as an increased percentage of resting hairs, sometimes approaching 100% (196). Features favoring lupus erythematosus include increased dermal mucin, focal basal vacuolization of infundibular epithelium, and inflammation around blood vessels and eccrine glands, particularly when the infiltrate is dense. Although androgenetic alopecia shows diminution of follicular size, dermal infiltrates that are present in this condition are usually superficial, perivascular, and peri infundibular. Using a comparison of clinical and histologic features, one paper discussed problematic differential diagnoses with respect to AA (214). |
|
Pathogenesis . The exact pathogenesis of AA is not known, but substantial evidence exists to support a role for genetic factors, nonspecific immune- and organ-specific autoimmune reactions, and environmental triggers . The antigenic stimulus for autoimmune attack may be the follicular keratinocyte, melanocyte, or dermal papilla. Advances in the understanding of alopecia areata in the last decade have benefited from animal models of the disease , including the C3H/HeJ mouse , the Dundee experimental bald rat , and the Smyth chicken . Quantitative and qualitative investigational guidelines for the study of AA were proposed in 1999 to facilitate collaboration among researchers, data comparison, and sharing of tissue specimens . |
|
Familial cases of AA are well recognized, suggesting a genetic predisposition . A family history of AA reportedly ranges between 10% and 42% , with higher incidences in patients with disease onset early in life and in identical twins . Alopecia areata has been associated with both HLA class I and class II antigens, with different forms and severity of AA found to be associated with certain HLA types . AA has been associated with many conditions, including Down’s syndrome, atopy, vitiligo, thyroid disease, pemicious anemia, diabetes, myasthenia gravis, lupus erythematosus, rheumatoid arthritis, ulcerative colitis, lichen planus, polymyalgia rheumatica, Candida endocrinopathy syndrome, and idiopathic thrombocytopenia purpura . |
|
In a study using indirect immunofluorescence, autoantibodies to various parts of the anagen hair follicle were found in AA patients . Most commonly targeted were the outer root sheath, then the matrix, inner root sheath, and hair shaft. Tobin et al. also found serum autoantibodies to pigmented hair follicles in 100% of AA patients but in only 44% of control patients . |
|
Earlier experiments showed the peri bulbar infiltrate to be composed predominantly of CD4+ cells (helper T lymphocytes) . Subsequently, CD8+ cells (suppressor-cytotoxic T lymphocytes) were implicated in the pathogenesis of AA , with experiments supporting a cooperative role between CD8+ and CD4+ T cells . Expression of cell adhesion molecules in the matrix epithelium, dermal papilla, and adjacent vessels has been demonstrated, suggesting a mechanism for leukocyte binding . The immune system of the hair follicle is unique and differs from that of the surrounding skin . The epithelial portion of the proximal anagen hair is immune privileged; the inner root sheath and hair matrix do not express major histocompatibility class (MHC) class I antigens . A theory put forth by Paus, an “immune privilege collapse model,” suggests that in AA, the body’s immune system may begin to recognize immuneprivileged hair follicle antigens as a result of upregulated MHC molecules or downregulation of local immunosuppressive factors . Cytokines may play an important role in AA. When serum cytokine levels were measured, it was found that IL-1 a and IL-4 (Th2 cytokines) were elevated in patients with localized AA, whereas interferon-y and IL-2 (Th1 cytokines) were significantly increased in AA patients with severe disease (alopecia universalis) . IL-1a, IL-1~, and tissue necrosis factor-a have been shown in vitro to produce changes in hair follicle morphology that resemble those in AA . In addition, a role for the peripheral nervous system has been postulated in AA, via neuropeptides with pro- and antiinflammatory properties released in the vicinity of critical areas of the hair follicle |